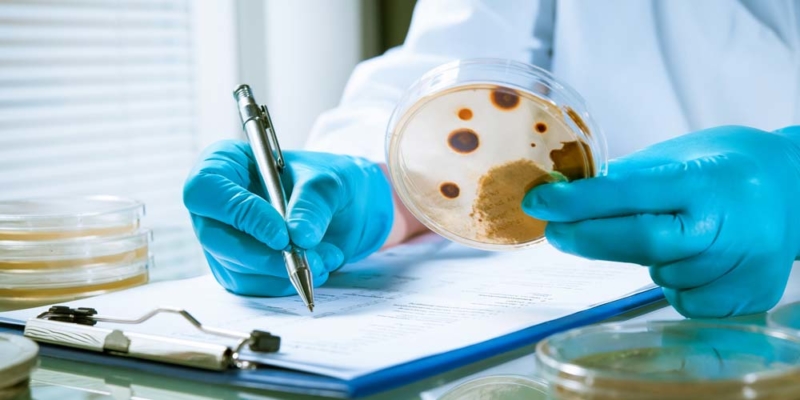

Your fitness club is supposed to be a health haven. But a new study shows that it’s teeming with germs.
“Every time you pick up a weight or grab an exercise bike handle, you could be putting yourself at risk for an illness or infection,” warns the report.
An environmental testing lab took bacterial samples from exercise equipment at three large fitness chains. Free weights were found to be the most germ-laden surface.
- Free weights contain up to 362 times more bacteria than a toilet seat.
- Exercise bikes house nearly 40 times more bacteria than plastic reusable cafeteria trays.
- Treadmills have 74 times more bacteria than a public bathroom faucet.
Each piece of equipment carried more than a million bacteria per square inch. Researchers speculate that free weights are the dirtiest because people don’t wipe them down as often as they do cardio machines.
It’s not just the fact that the bacteria are there, it is the type of bacteria that is so alarming. More than 70% of the germs found in gyms are potentially harmful to humans. They include bacteria that cause pneumonia, skin infections, and sepsis.
7 Ways to Stay Safe In The Gym
Here are simple strategies to avoid getting sick while using your fitness club:
- Bandage it. Be sure to cover any cuts or broken skin with a bandage before you go to the gym.
- Disinfect twice. Use the disinfecting wipes provided by most fitness clubs both before and after using equipment.
- Never go barefoot. Use flip-flops or some other foot covering when using the locker room area.
- Keep your hands down. Avoid touching your face during a workout. This transfers germs from the equipment to points of entry to your body, such as your eyes, mouth, or ears. If you need to wipe your face, use a clean towel.
- Wash your hands. Do this immediately after your workout before you leave the gym. You may even want to use hand sanitizer when you move from one piece of equipment to another.
- Watch where you sit. Never sit on a locker room bench naked. Put down a clean towel first.
- Do a quick change. Don’t linger in your gym clothes. As soon as you are done with your workout, hit the showers and get into clean clothing.